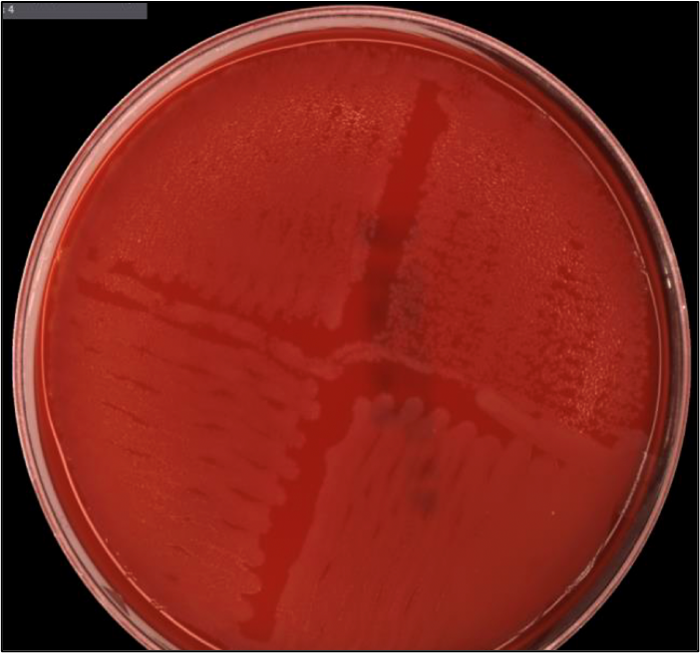

Case Description
An elderly woman presented to the emergency department with sudden onset diarrhea, fever and altered mental status for 1 day. On admission, she had fever with chills, tachycardia, tachypnea, and diminishing mental status. Her white blood cell (WBC) count was slightly elevated from baseline with neutrophilia and thrombocytopenia. Blood and CSF were sent for bacterial culture. Stool was sent for C. difficile PCR and occult blood, which came back negative.
Organisms were recovered from the aerobic blood culture bottle. Gram stain showed gram positive short rods. A multiplex PCR was run directly from the blood, which detected Listeria monocytogenes. The care team was notified immediately. The organism grew on blood agar and aerobic Columbia Naladixic Acid Agar (CNA agar) with characteristic beta hemolysis. The identification was re-confirmed by MALDI-TOF MS as Listeria monocytogenes.
Discussion
Listeria monocytogenes is an intracellular Gram positive rod that is pathogenic to humans. The organism is a non-spore forming facultative anaerobe which thrives at low temperature and can survive at low pH and high salt concentration, making it an organism of concern in ready to eat- refrigerated food products, including soft cheese, deli meat, and packaged salads. There have been multiple outbreaks of Listeria infection related to certain these food products. The most recent Listeria outbreaks, as per the CDC’s report December 2021, has been linked to Dole packaged salads.
The primary route of infection with Listeria is oral ingestion. The amount of inoculum ingested is responsible for the degree of severity of infection. Most people get noninvasive gastroenteritis, which is self-limited, and recovery typically occurs within a week of infection with supportive treatment. Invasive infection is mostly seen in immunocompromised people, people with hematologic malignancies, chronic illnesses like diabetes, pregnant individuals, and extremes of ages. Infected pregnant woman can transmit the infection to fetus vertically, which can lead to fetal demise. Because of this, pregnant women are advised to avoid foods where Listeria is often found, such as deli meat. The infection rate in US currently is 24 cases per thousand and around 800 cases are reported annually, this number does not include the cases that are unreported which is most likely comprised of the noninvasive gastroenteritis cases.1,2,5
Invasive disease can range from severe form of gastroenteritis to meningoencephalitis. The fetal infection with Listeria is known to result in the most severe form of outcomes ranging from granuloma infantisepticum to fetal demise in utero. Bacteria enter the gastrointestinal tract through the intestinal lining. Upon entry, the bacteria travel intracellularly through the lamina propria into the vascular system and get disseminated throughout the body including the brain and placenta in pregnant woman.1,2,5
Bacterial culture remains the gold standard, of which blood culture is the most sensitive test when it comes to invasive diseases. Blood culture takes about 24 hours to grow the organism. Listeria can be cultured in media containing horse, sheep or rabbit blood. Listeria produces smooth, round, translucent colonies with a narrow zone of beta- hemolysis. Listeria can be morphologically difficult to differentiate from other Gram positive rods. In these cases, simple biochemical tests can help identify the organism. For example, catalase test, esculin test, oxidase test that are typically positive in case of Listeria, while H2S and indole are not produced by the organism and urea and gelatin are not hydrolyzed. Additionally, hanging drop method can help demonstrate the characteristic tumbling motility of the organism. With motility agar, Listeria demonstrates an umbrella motility pattern. Direct identification of organism from a positive blood culture, CSF or tissue specimen by using PCR assays should be performed, when available, and is particularly useful in patient who have undergone antimicrobial therapy. There is microarray based nucleic acid test available that can identify Listeria from blood culture within 3 hours. MALDI-TOF mass spectrometry is an efficient assay for rapid identification of L. monocytogenes once an organism is recovered in culture.2.6
For the treatment of severe listeriosis in at risk populations, ampicillin is commonly used and aminoglycosides can be added for synergy. Trimethoprim/sulfamethoxazole (TMP/SMX) can be given in case of Beta-lactam allergy. Listeria is intrinsically resistant to cephalosporins and therefore these agents should not be used for therapy. In case of suspected treatment failures, antimicrobial susceptibility testing can be performed as per the available CLSI guidelines, which provides susceptibility breakpoints for penicillin, ampicillin, TMP/SMX and meropenem.2,6 Our patient received ampicillin along with gentamicin for her symptoms and recovered well.
References
- Radoshevich, L., Cossart, P. Listeria monocytogenes: towards a complete picture of its physiology and pathogenesis. Nat Rev Microbiol 16, 32–46 (2018). https://doi.org/10.1038/nrmicro.2017.126
- https://www.cdc.gov/listeria/index.html
- Bierne, H. & Cossart, P. When bacteria target the nucleus: the emerging family of nucleomodulins. Cell. Microbiol. 14, 622–633
- Boujemaa-Paterski, R. et al. Listeria protein ActA mimics WASP family proteins: it activates filament barbed end branching by Arp2/3 complex. Biochemistry 40, 11390–11404 (2001)
- Lancet Infect Dis. 2017;17(5):510. Epub 2017 Jan 28
- Nele Wellinghausen
- , 2019. Listeria and Erysipelothrix, Manual of Clinical Microbiology, 12th Edition. ASM Press, Washington, DC. doi: 10.1128/9781683670438.MCM.ch28

-Kritika Prasai, MD. is a PGY-1 Anatomic and Clinical Pathology resident at University of Chicago (NorthShore).

-Paige M.K. Larkin, PhD, D(ABMM), M(ASCP)CM is the Director of Molecular Microbiology and Associate Director of Clinical Microbiology at NorthShore University HealthSystem in Evanston, IL. Her interests include mycology, mycobacteriology, point-of-care testing, and molecular diagnostics, especially next generation sequencing.
Very informative!!!